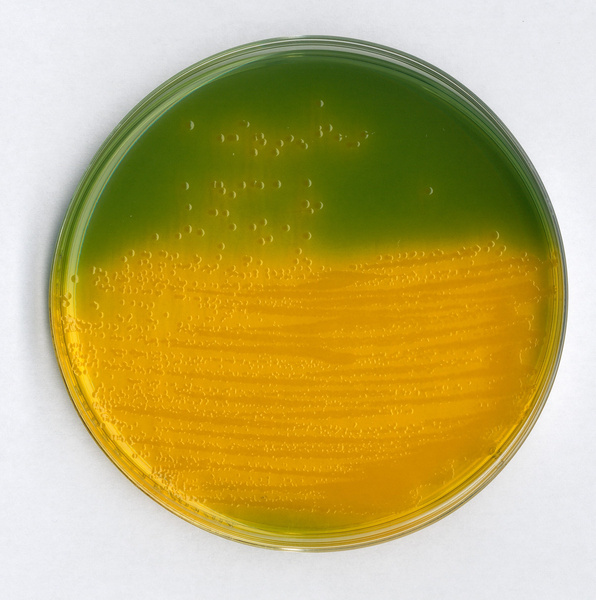
默克密理博milliporetcbs培养基1.10263.0500

tcbs培养基

h2s阴性tcbs琼脂微生物灵敏度试验:按标签用法制备培养基,接种以下
图片尺寸741x746
默克密理博milliporetcbs培养基1.10263.0500
图片尺寸596x600
tcbs培养基
图片尺寸800x800
tcbs培养基
图片尺寸650x360
在tcbs平板上的各种颜色的菌落具体是什么细菌?谢谢
图片尺寸2592x1944
快速弧菌检测培养基 tcbs琼脂平板 平皿水产弧菌总菌检测品质保证
图片尺寸720x478
tcbs 水产弧菌检测培养基 250g/瓶 硫柠胆蔗琼脂
图片尺寸800x800
tcbs琼脂培养基平板9cm水产弧菌快速检测试剂盒真空独立包装弧菌
图片尺寸800x800
tcbs培养基
图片尺寸1440x1920
tcbs琼脂培养基平板9cm水产弧菌快速检测试剂盒真空独立包装独立
图片尺寸800x800
久聚和tcbs琼脂培养基br250g/瓶干粉培养基广东环凯025020
图片尺寸800x800
计数 孟加拉红 营养琼脂 月桂基盐胰蛋白胨煌绿乳糖胆盐肉 tcbs琼脂
图片尺寸800x800
tcbs琼脂-霍乱弧菌
图片尺寸600x600
tcbs培养基培养出来的是什么菌?急急急,谢谢
图片尺寸500x373
斯永达现货tcbs琼脂培养基干粉250g硫柠蔗琼脂水产养殖弧菌北京陆桥
图片尺寸800x800
h2s阴性tcbs琼脂微生物灵敏度试验:按标签用法制备培养基,接种以下
图片尺寸741x746
tcbs琼脂培养基br250g广东环凯硫代硫酸钠柠檬柠檬酸试剂
图片尺寸800x800
仁聚益定制新批次北京陆桥平板计数tcbs结晶紫中性红胆盐营养琼脂培养
图片尺寸800x800
北京陆桥 细菌微生物培养基tcbs琼脂250g瓶装粉末水产弧菌快速检测
图片尺寸800x800
tcbs琼脂培养基干粉250g硫柠蔗琼脂水产养殖弧菌北京陆桥青岛海博
图片尺寸850x850